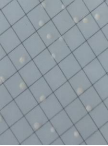

| 序号 | 022075 | ||||||||
| 中文名 | m TGE肉汤 022075 | ||||||||
| 英文名 | m TGE Broth | ||||||||
| 用途 | 用于滤膜法细菌总数计数。 | ||||||||
| 标准 | |||||||||
| 配方(g/L) | 成分 含量(g/L) 牛肉粉 6.0 胰胨 10.0 葡萄糖 2.0 最终 pH 7.0±0.2 |
||||||||
| 原理 | 胰蛋白和牛肉粉胨提供碳氮源、维生素和生长因子;葡萄糖为可发酵的糖。 | ||||||||
| 用法 | 称取本品干粉18g,加入蒸馏水或去离子水1 L,搅拌加热煮沸至完全溶解,121℃高压灭菌15 min。(注:配制不同用量体积,可按比例扩增或缩小。) | ||||||||
| 质量控制 | 1. 外观方面: 脱水干粉培养基:淡黄色粉末。 2. 生物学方面 下列质控菌株接种待测试培养基,35±2℃培养18~24h,结果如下:
金黄色葡萄球菌 大肠埃希氏菌 |
||||||||
| 相关培养基 | |||||||||
| 图片 | |||||||||
| 发布时间 | 2019-07-23 |